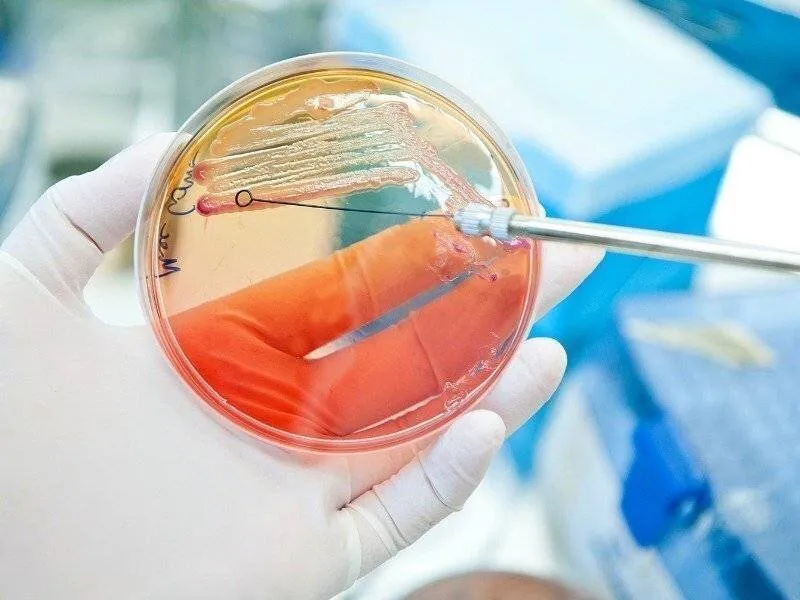

Proteus mirabilis transmission symptômes traitement
Les Proteus sont un genre de bactéries uropathogènes majeures (c’est à dire responsables d’infections urinaires) qui peuvent également infecter la peau et les tissus (plaies, abcès divers), explique le Dr Lionel Barrand, biologiste. Ces bactéries sont souvent impliquées dans des infections nosocomiales (deux tiers des infections à Proteus sont d’origine hospitalière, les infections urinaires étant les plus fréquentes). En laboratoire, la bactérie Proteus mirabilis dégage une forte odeur qui rappelle celle du poisson pourri.
Q: Proteus mirabilis : c’est quoi ?
R: Les Proteus sont un genre de bactéries uropathogènes majeures qui peuvent également infecter la peau et les tissus. La bactérie Proteus mirabilis dégage une forte odeur qui rappelle celle du poisson pourri.
Q: Comment se transmet la bactérie Proteus mirabilis ?
R: Les bactéries du genre Proteus se retrouvent très fréquemment dans l’environnement, notamment dans le sol, les eaux de surface et les eaux usées. La contamination se fait généralement par colonisation du périnée depuis le tube digestif jusqu’au méat urinaire. La transmission directe inter-humaine est extrêmement rare.
Q: Quels sont les symptômes d’une infection à Proteus mirabilis ?
R: Les symptômes sont ceux d’une infection urinaire (cystite) : des brûlures lors des mictions, des envies fréquentes d’uriner, une urine trouble et parfois malodorante. Si l’infection remonte de la vessie jusqu’aux reins apparaissent alors de la fièvre, des frissons, des douleurs lombaires. Chez l’homme, l’ensemble de ces symptômes peut être constaté si l’infection concerne la prostate.
Q: Comment détecter la bactérie Proteus mirabilis ?
R: On peut détecter la bactérie lors d’une mise en culture d’un prélèvement urinaire (ECBU) ou d’un prélèvement cutané.
Q: Quel est le traitement pour une infection à Proteus mirabilis ?
R: Étant donné que Proteus mirabilis est une bactérie, la prise d’antibiotiques est donc indiquée pour guérir les patients infectés. Pour une infection urinaire non compliquée chez la femme – cas le plus fréquent – l’antibiothérapie de première intention repose sur la fosfomycine (Monuril) en une prise unique (sachet de 1 g). Ces remèdes ne remplacent en aucun cas l’antibiothérapie.
Q: Y a-t-il des remèdes naturels pour traiter une infection à Proteus mirabilis ?
R: La canneberge (en jus ou en poudre) contribue à diminuer la fixation des Proteus sur les parois des voies urinaires et donc prévenir les infections urinaires. De plus, des chercheurs de l’Université McGill et de l’Institut national de la recherche scientifique (INRS) ont démontré qu’un extrait du petit fruit acidulé rendrait ces bactéries plus sensibles aux antibiotiques et les empêcherait de développer une résistance. Cependant, ces remèdes ne remplacent en aucun cas l’antibiothérapie.
Q: Les infections à Proteus mirabilis sont-elles fréquentes ?
R: Oui, les infections à Proteus mirabilis sont relativement fréquentes et représentent environ 10% des infections urinaires nosocomiales. Elles touchent généralement les personnes hospitalisées, les patients atteints de troubles neurologiques et les personnes présentant des anomalies du système urinaire.
Q: Les infections à Proteus mirabilis sont-elles dangereuses ?
R: Dans la plupart des cas, les infections à Proteus mirabilis sont bénignes et se traitent facilement avec des antibiotiques. Cependant, dans les cas les plus graves, les infections à cette bactérie peuvent provoquer des complications telles qu’une pyélonéphrite (infection des reins) ou une septicémie.
Q: Comment prévenir les infections à Proteus mirabilis ?
R: La prévention des infections à Proteus mirabilis passe par une bonne hygiène, notamment en se lavant régulièrement les mains, en utilisant des matériaux stériles pour les cathéters et les sondes urinaires, et en évitant les comportements à risque tels que l’utilisation de douches vaginales. Il est également important de boire suffisamment d’eau pour favoriser l’élimination des bactéries de l’organisme.
Dans cet article, nous avons vu que les Proteus mirabilis sont des bactéries uropathogènes majeures, responsables d’infections urinaires et que ces bactéries peuvent également infecter la peau et les tissus. Nous avons également vu comment la bactérie se transmet, les symptômes d’une infection à Proteus mirabilis, comment la détecter et les traitements possibles, y compris l’utilisation d’antibiotiques et de remèdes naturels comme la canneberge.
Il est important de noter que les antibiotiques sont la méthode la plus efficace pour traiter les infections à Proteus mirabilis. Si vous pensez être infecté par cette bactérie, il est important de consulter rapidement un médecin pour obtenir un diagnostic précis et un traitement approprié. Les remèdes naturels peuvent être utiles en complément du traitement médicamenteux, mais ne doivent en aucun cas le remplacer.
En conclusion, il est essentiel de prendre soin de notre santé en adoptant des comportements d’hygiène appropriés, tels que le lavage des mains et le nettoyage régulier des surfaces. En cas de symptômes d’infection urinaire, il est important de consulter rapidement un professionnel de la santé pour éviter que l’infection ne s’aggrave.